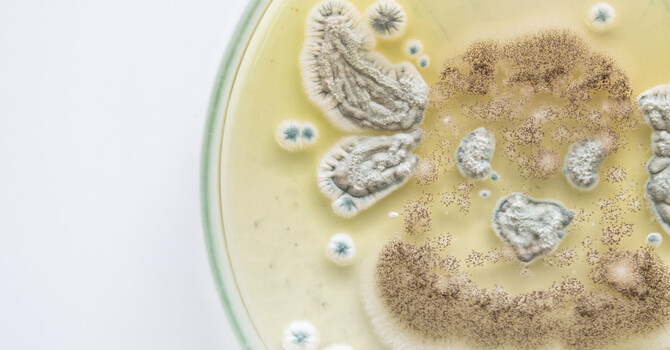
Ozone for Mold in San Diego image

Our Blog
Welcome to WeAreTulsi, your ultimate destination for holistic wellness insights and inspiration. Dive into a world where ancient wisdom meets modern lifestyle, guiding you towards a balanced and fulfilling life.
At WeAreTulsi, we curate the finest content to nurture your mind, body, and spirit. From enlightening articles on mindfulness and nutrition to expert tips on yoga and meditation, our blog is your trusted companion on the journey to wellness.
Join a community of like-minded individuals who prioritize self-care and personal growth. Whether you're a seasoned wellness enthusiast or just starting your path, WeAreTulsi offers something for everyone. Our aim is to coninute to provide information that anyone can digest and build a healthier version of themselves. We will continue to update this information weekly and will also be available in our newsletter.
Explore our blog today and embark on a transformational journey towards a healthier, happier you. Embrace the power of holistic living with WeAreTulsi - because your well-being matters. Afterall a healthier community is a better community. #wearetulsi